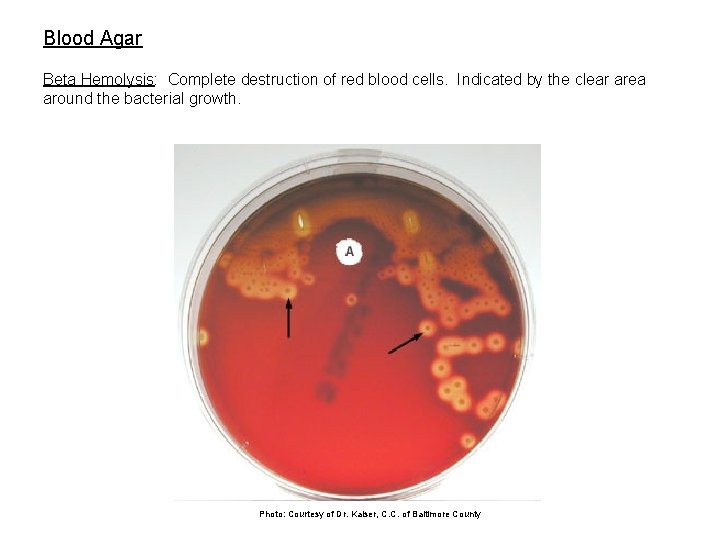
Blood Agar Beta Hemolysis: Complete destruction of red blood cells. Indicated by the clear

Gram Positive Staphylococci Note the purple sphericallyshaped clustered

- Slides: 14
Gram Positive Staphylococci – (Note the purple, sphericallyshaped, clustered cells)
Gram Negative Bacilli – (Note the pink, rod-shaped cells)
Acid-Fast staining: Below is a mixed culture of acid fast bacteria (red; such as the Mycobacteria, B) and non-acid-fast bacteria (blue, A)
Spore staining: Spores are stained blue (B); vegetative cells are stained red (A). Photo: Courtesy of Western Michigan University
Ex. 5 -13 – Casein hydrolysis on Milk agar Photo: Courtesy of Austin Community College
Ex. 5 -11 - Starch Hydrolysis Photo: Courtesy of Austin Community College
Phenylethylalcohol (PEA): Is this media selective or differential? Why? A= Staphlylococcus aureus B= Escherichia coli C= S. aureus + E. coli
Gelatin Hydrolysis: Some bacteria have enzymes which breakdown the gelatin (which is protein) to amino acids; as indicated by liquefaction in test tube B. Remember: Besides the fact that most bacteria are unable to digest agar, agar is superior to gelatin because it remains solid well above room temperature (~25°C). Whereas gelatin begins to melt around 25°C.
Mac. Conkey Agar: Selective: inhibits growth of Gram positive bacteria. Differential: distinguishes between lactose fermenters and non-fermenters. Escherichia coli is growing on the right plate. It is Gram negative, ferments lactose, and produces a red coloration on and around its growth. Salmonella typhimurium is growing on the left plate. It is Gram negative, does not ferment lactose, and is colorless. What is a coliform bacterium? What ingredient makes Mac. Conkey agar selective? What is the p. H indicator in this media? What does it do? Photos: Courtesy of Austin Community College
Eosin Methylene Blue (EMB) Agar: Lactose fermenters produce colored colonies on EMB and non-lactose fermenters produce colorless colonies (see lab book photos). The green metallic sheen shown on the plate below is characteristic of Escherichia coli. Is EMB a selective or differential media? What are the dyes in EMB? Photo: courtesy of Dr. Kaiser
Mannitol Salt Agar: 1. Staphlylococcus aureus 2. Staphylococcus epidermidis (there is growth, but its not visible). Why does S. aureus produce a yellow color? Why doesn’t S. epidermidis produce a yellow color? Is MSA selective or differential? What media components make it selective and/or differential? Photo: Courtesy of Austin Community College
Blood Agar Gamma Hemolysis: No destruction of red blood cells Is blood agar selective, differential or enriched? Photo: Courtesy of Dr. Kaiser, C. C. of Baltimore County
Blood Agar Alpha Hemolysis: Partial destruction of red blood cells. Indicated by the greenish coloration of the media around the bacterial growth. Photo: Courtesy of Dr. Kaiser, C. C. of Baltimore County
Blood Agar Beta Hemolysis: Complete destruction of red blood cells. Indicated by the clear area around the bacterial growth. Photo: Courtesy of Dr. Kaiser, C. C. of Baltimore County